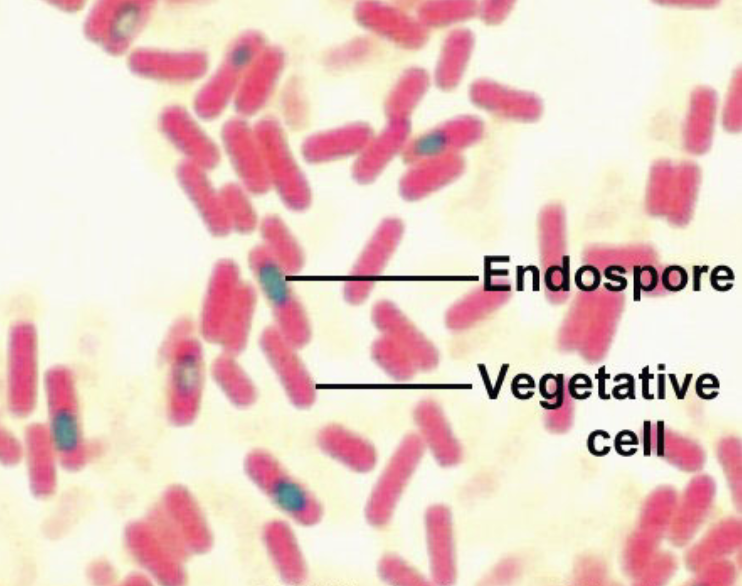
What kind of staining is this?

Lab 4, pt. 2: Differential Stains II
0.0(0)
Card Sorting
1/19
Last updated 12:31 AM on 3/21/23
Name | Mastery | Learn | Test | Matching | Spaced | Call with Kai |
|---|
No analytics yet
Send a link to your students to track their progress
20 Terms
1
New cards
What is the point of differential stains?
To identify a specific property of certain cells in a complex sample
2
New cards
What is gram staining?
differential staining technique that provides an easy differentiation of bacteria into one of two groups
3
New cards
Name some characteristics in **gram-positive cell walls**
* **Thick** peptidoglycan
* 90% peptidoglycan
* teichoic acids
* 1 layer
* not many polysaccharides
* 90% peptidoglycan
* teichoic acids
* 1 layer
* not many polysaccharides
4
New cards
Name some characteristics in **gram-negative cell walls**
* **Thin** peptidoglycan
* 5-10% peptidoglycan
* No teichoic acids
* 3 layers
* Outer membrane has lipids, polysaccharides
* 5-10% peptidoglycan
* No teichoic acids
* 3 layers
* Outer membrane has lipids, polysaccharides
5
New cards
What does ethanol do in the gram-staining procedure?
Removes stain from **Gram Negatives** but not **Gram Positives**
6
New cards
What are the 4 conditions to be followed for a Gram staining procedure?
* young cultures (18-24hrs old)
* thin smear
* fresh reagents (of proper strength)
* control cultures
* thin smear
* fresh reagents (of proper strength)
* control cultures
7
New cards

Gram stained slides of…
Neisseria
8
New cards

Gram stained slides of…
Streptococcus
9
New cards

Gram stained slides of…
Pseudomona
10
New cards
What kind of staining is this?
Endospore staining
11
New cards
What is an **endospore**? What do they germinate into?
* Dormant and highly resistant cell which contains a copy of the cellular DNA
* Endospores germinate into **vegetative cells** when nutrients are around
* Endospores germinate into **vegetative cells** when nutrients are around
12
New cards

What kind of stain is this?
* Acid-fast Stain
* Mycobacteria
* Mycobacteria
13
New cards
Name some characteristics of the acid-fast bacterial cell wall
* Thick cell walls
* 60% lipids - little peptidoglycan
* Doesn’t stain well
* 60% lipids - little peptidoglycan
* Doesn’t stain well
14
New cards
What bacteria is used for acid-fast stains?
Mycobacterium
15
New cards

What kind of colonies are these?
Mycobacterium tuberculosis colonies
16
New cards

What example of acid-fast staining is this?
Mycobacterium tuberculosis
17
New cards

What example of acid-fast staining is this?
Mycobacterium leprae
18
New cards

What example of acid-fast staining is this?
Mycobacterium marinum
19
New cards
What colors do spores stain?
Green
20
New cards
What color does vegetative cells stain?
Red/pink